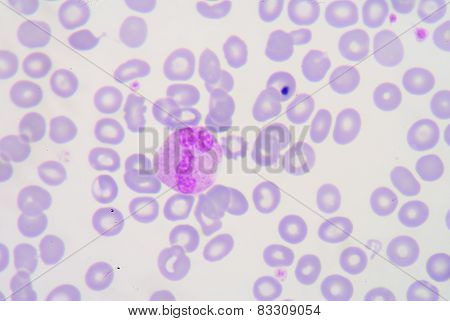
Neutrophils Are A Type Of Phagocyte And Are Normally Found In The Bloodstream. During The Beginning

Economize com um plano de assinatura. Saiba mais >
fechar
Imagem
Imagens
fagócito
Bancos de imagens
(Resultados totais: 1,011)